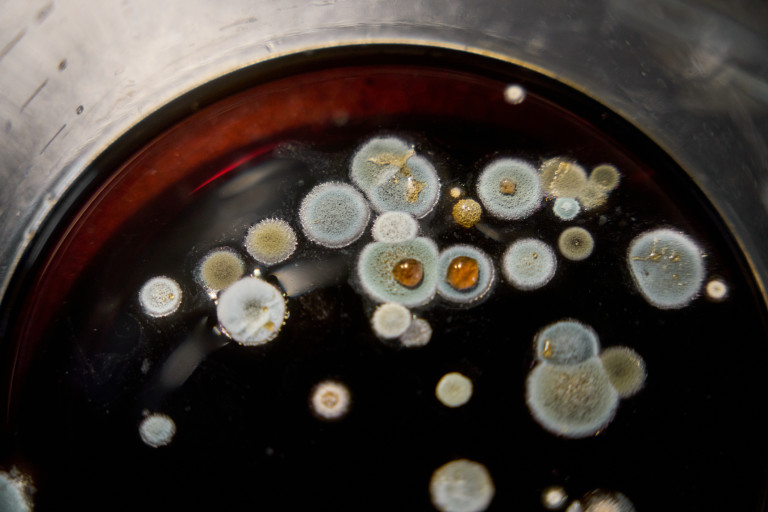
Снимка 724618

7 вредни навика, които забавят метаболизма ни
Дали метаболизмът ни е бърз или муден зависи от разнообразни фактори. И до момента в който върху някои от тях нямаме надзор, то върху други може да повлияем. Така да вземем за пример няма по какъв начин да съпротивляваме против напредването на годините, което неизбежно забавя метаболизма. Но пък може да променим някои нездравословни привички, с които го саботираме, евентуално даже без са осъзнаваме.
5 от най-лошите храни и питиета, които да консумираме след 45 година
С напредването на годините би трябвало да се внимава от ден на ден
Ето седем нездравословни навика, които могат да доведат до закъснение на метаболизма.
Прекарване на време пред електронни устройства преди сън
Качеството на съня ни се отразява и на метаболизма. А доста хора имат навика да прекарват време пред електронни устройства директно преди сън.

Синята светлина, която излъчват те обаче, обърква циркадния ни темп и даже може да способства за отключването на инсулинова устойчивост.
Недоспиване и неприятно качество на съня
Както към този момент споменахме, сънят и метаболизмът са свързани. Когато не спим задоволително и не спим качествено, това също може да го забави.

Дори и единствено една нощ, в която не сме спали добре, може да повлияе отрицателно на хормоните на глада и инсулиновата сензитивност.
Недостатъчен банкет на протеини
Когато не ядем задоволително храна, богата на протеини, не би било изненадващо, в случай че метаболизмът ни е муден. Те оказват помощ за възобновяване на тъканите, в това число и след подготовка, както и за възприятието на задоволеност.

И не на последно място, протеините също по този начин ни оказват помощ за построяването и поддържането на мускули. А колкото повече мускулна маса имаме, толкоз повече калории ще изгаряме даже и неподвижен.
Недостатъчен банкет на въглехидрати за сметка на повече мазнини
Недостатъчният банкет на въглехидрати за сметка на повече мазнини е присъщ за кето диетата. Но в случай че не си набираме задоволително въглехидрати за прекомерно нескончаем интервал от време, това може да докара до намалени равнища на хормоните на щитовидната жлеза. А тя има основна роля за метаболизма ни.

Когато равнищата на хормоните ѝ са занижени, може да стартираме да усещаме отмалялост, тромавост, както и да видим, че по-лесно качваме килограми.
Неподходящи тренировки
Ако акцентираме прекалено много на кардио тренировките, си вършим неприятна услуга - посредством тях действително изгаряме и мускулна тъкан. Полезно е да знаем, че мускулите са доста метаболитно дейни и колкото повече мускулна маса имаме, толкоз по-бърз е метаболизма ни.

Но дългите и изтощителни кардио тренировки освен че се отразяват отрицателно, в случай че се стремим към повишаване на мускулна маса - те покачват и кортизола. А когато този хормон и непрекъснато нараснал, това алармира на организма да натрупва мазнини, изключително в коремната област.
Консумация на мухлясало кафе
Поради способи, по които се обработва и съхранява, в кафето може да попаднат микотоксини - токсични метаболитни артикули на плесените и мухъла.

Те са изключително нездравословни за черния дроб и бъбреците. Освен това въздействат отрицателно и на хормоните ни, и може да доведат до закъснение на метаболизма.
Най-големият мит: повече кардио = по-добър метаболизъм
Ето за какво
Консумация на алкохол
Алкохолът, даже и в дребни количества, забавя метаболизма. Съветът на здравните специалисти е въобще де не го консумираме, защото поврежда както черния дроб, по този начин и мозъка.

Когато черния ни дроб е ангажиран със задачата да се оправи с алкохола в организма ни, той не може да метаболизира вярно мазнините и захарите. А това надлежно води до наддаване на тегло и други съществени проблеми и чернодробни болести, написа.
5 от най-лошите храни и питиета, които да консумираме след 45 година
С напредването на годините би трябвало да се внимава от ден на ден
Ето седем нездравословни навика, които могат да доведат до закъснение на метаболизма.
Прекарване на време пред електронни устройства преди сън
Качеството на съня ни се отразява и на метаболизма. А доста хора имат навика да прекарват време пред електронни устройства директно преди сън.

Синята светлина, която излъчват те обаче, обърква циркадния ни темп и даже може да способства за отключването на инсулинова устойчивост.
Недоспиване и неприятно качество на съня
Както към този момент споменахме, сънят и метаболизмът са свързани. Когато не спим задоволително и не спим качествено, това също може да го забави.

Дори и единствено една нощ, в която не сме спали добре, може да повлияе отрицателно на хормоните на глада и инсулиновата сензитивност.
Недостатъчен банкет на протеини
Когато не ядем задоволително храна, богата на протеини, не би било изненадващо, в случай че метаболизмът ни е муден. Те оказват помощ за възобновяване на тъканите, в това число и след подготовка, както и за възприятието на задоволеност.

И не на последно място, протеините също по този начин ни оказват помощ за построяването и поддържането на мускули. А колкото повече мускулна маса имаме, толкоз повече калории ще изгаряме даже и неподвижен.
Недостатъчен банкет на въглехидрати за сметка на повече мазнини
Недостатъчният банкет на въглехидрати за сметка на повече мазнини е присъщ за кето диетата. Но в случай че не си набираме задоволително въглехидрати за прекомерно нескончаем интервал от време, това може да докара до намалени равнища на хормоните на щитовидната жлеза. А тя има основна роля за метаболизма ни.

Когато равнищата на хормоните ѝ са занижени, може да стартираме да усещаме отмалялост, тромавост, както и да видим, че по-лесно качваме килограми.
Неподходящи тренировки
Ако акцентираме прекалено много на кардио тренировките, си вършим неприятна услуга - посредством тях действително изгаряме и мускулна тъкан. Полезно е да знаем, че мускулите са доста метаболитно дейни и колкото повече мускулна маса имаме, толкоз по-бърз е метаболизма ни.

Но дългите и изтощителни кардио тренировки освен че се отразяват отрицателно, в случай че се стремим към повишаване на мускулна маса - те покачват и кортизола. А когато този хормон и непрекъснато нараснал, това алармира на организма да натрупва мазнини, изключително в коремната област.
Консумация на мухлясало кафе
Поради способи, по които се обработва и съхранява, в кафето може да попаднат микотоксини - токсични метаболитни артикули на плесените и мухъла.
Те са изключително нездравословни за черния дроб и бъбреците. Освен това въздействат отрицателно и на хормоните ни, и може да доведат до закъснение на метаболизма.
Най-големият мит: повече кардио = по-добър метаболизъм
Ето за какво
Консумация на алкохол
Алкохолът, даже и в дребни количества, забавя метаболизма. Съветът на здравните специалисти е въобще де не го консумираме, защото поврежда както черния дроб, по този начин и мозъка.

Когато черния ни дроб е ангажиран със задачата да се оправи с алкохола в организма ни, той не може да метаболизира вярно мазнините и захарите. А това надлежно води до наддаване на тегло и други съществени проблеми и чернодробни болести, написа.
Източник: lifestyle.bg
КОМЕНТАРИ




